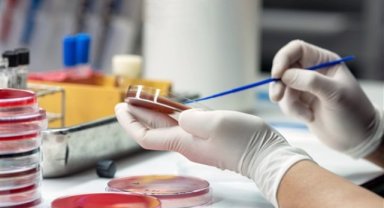
Sepsiste ilk saatlerde müdahale hayat kurtarıyor

İçişleri Bakanlığından yapılan açıklama, şu bilgiler verildi:
''İçişleri Bakanlığı koordinesinde Emniyet Genel Müdürlüğü ve Jandarma Genel Komutanlığına bağlı personelin katılımı ile 81 ilde eş zamanlı olarak asayiş, çocuk, narkotik, TEM ve KOM birimlerinden oluşturulan karma ekiplerle bugünden itibaren 5 gün boyunca çocuk ve gençlerin korunmasına yönelik okul çevreleri denetim uygulaması yapılacak. 07.30-18.00 saatleri arasında, okulların giriş çıkış ve öğle arası saatlerindeki yoğunluk göz önünde bulundurulmak suretiyle denetim süresi en az 2'şer saatlik dilimlerden oluşan 3 periyot halinde planlanarak tüm ilkokul, ortaokul, lise ve öğrenci yurtlarının yakın çevresinde okulla ilişkisi bulunmayan şüpheli şahıslara yönelik ve bu yerlerin yakınındaki park ve bahçeler, metruk binalar, alkol ve tütün mamülleri satışı yapılan yerler, içkili yerler, iddia ve ganyan bayileri, kahvehaneler, internet ve elektronik oyun salonları gibi umuma açık yerler denetlenecek. Ülke genelinde yıl boyu sürecek bu denetimler okulların açıldığı bu hafta ise 5 gün boyunca yoğunlaştırılacak. 5 günlük yoğun denetimde emniyet ve jandarma birimlerinden oluşturulan 16.948 karma ekip ile 56.948 personel katılım sağlayacak."
''İçişleri Bakanlığı koordinesinde Emniyet Genel Müdürlüğü ve Jandarma Genel Komutanlığına bağlı personelin katılımı ile 81 ilde eş zamanlı olarak asayiş, çocuk, narkotik, TEM ve KOM birimlerinden oluşturulan karma ekiplerle bugünden itibaren 5 gün boyunca çocuk ve gençlerin korunmasına yönelik okul çevreleri denetim uygulaması yapılacak. 07.30-18.00 saatleri arasında, okulların giriş çıkış ve öğle arası saatlerindeki yoğunluk göz önünde bulundurulmak suretiyle denetim süresi en az 2'şer saatlik dilimlerden oluşan 3 periyot halinde planlanarak tüm ilkokul, ortaokul, lise ve öğrenci yurtlarının yakın çevresinde okulla ilişkisi bulunmayan şüpheli şahıslara yönelik ve bu yerlerin yakınındaki park ve bahçeler, metruk binalar, alkol ve tütün mamülleri satışı yapılan yerler, içkili yerler, iddia ve ganyan bayileri, kahvehaneler, internet ve elektronik oyun salonları gibi umuma açık yerler denetlenecek. Ülke genelinde yıl boyu sürecek bu denetimler okulların açıldığı bu hafta ise 5 gün boyunca yoğunlaştırılacak. 5 günlük yoğun denetimde emniyet ve jandarma birimlerinden oluşturulan 16.948 karma ekip ile 56.948 personel katılım sağlayacak."